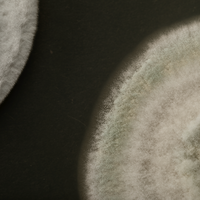

Aplicación
Aplicación terrestre: Metarril WP E9 debe ser aplicado en forma líquida, por medio de pulverizadores de barra o costal, con el chorro de pulverización dirigido a la base de la planta, pudiendo ser adaptado con todo tipo de abanico.
Aplicar en días con temperaturas templadas y humedad relativa dei aire superior ai 70%.
Aplicación aérea: Metarril WP E9 debe aplicarse a través de aeronaves agrícolas equipadas con barra de pulverización, siendo la altura ideal dei vuelo de 3 a 4 metros sobre el cultivo. Aplicar en días con una temperatura amena y una humedad relativa dei aire superior ai 70.